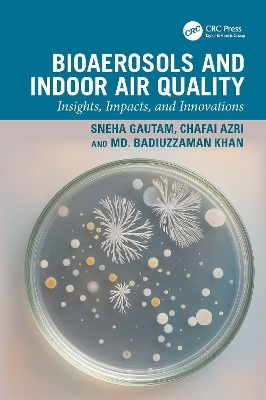
Bioaerosols and Indoor Air Quality - Sneha Gautam, Chafai Azri, Md. Badiuzzaman Khan

Bioaerosols and Indoor Air Quality
CRC Press (Verlag)
978-1-041-11011-8 (ISBN)
- Noch nicht erschienen (ca. März 2026)
- Versandkostenfrei
- Auch auf Rechnung
- Artikel merken
Provides detailed explanation of bioaerosol transport and mitigation strategies
Promotes comprehensive interdisciplinary approach integrating science, engineering, and public health
Reviews case studies and examples including real-world applications in healthcare, schools, and residential spaces
Discusses up-to-date advancements in air purification technologies and HVAC systems
Includes ancillary materials like end-of-chapter problems, solutions, lecture slides, and downloadable figures
This book is aimed at senior undergraduate, graduate students, researchers and professionals in air quality, aerosols, and bioaerosols.
Sneha Gautam Sneha is an Associate Professor in the Division of Civil Engineering at Karunya Institute of Technology and Sciences, Coimbatore, India. He earned his PhD (Engineering) from the Indian Institute of Technology, Kharagpur, and an MTech (Environmental Science and Engineering) from IIT-ISM Dhanbad. After his PhD, he joined INCLEN and the University of California, Berkeley, as a researcher, followed by a Post-Doctoral Fellowship from the Ministry of Science and Technology, Taiwan, and pursued postdoctoral research at NCTU, Taiwan. His name has been featured consecutively (2021–2024) in Stanford University’s Top 2% Scientists of the World list. He has received numerous awards, including the Young Scientist Award 2023 by the Academy of Sciences, Chennai, Young Scientist Award 2022, IEI Special Appreciation Award 2021, IEI Young Achiever Award 2020, IEI Young Scientist Award 2019, Outstanding Reviewer Award from Elsevier, and an International Travel Grant from the Government of India. He also serves as an Editor, Associate Editor, and Editorial Board Member and Guest Editor for several high-impact journals. With over 170 articles in leading journals (h-index 41, i10-index 104, and over 5869 citations), he has developed a global network of collaborators, and his research has been featured in prominent media outlets such as Al Jazeera, The Times of India, and Trinity. Chafai Azri is a professor at the Faculty of Sciences, University of Sfax, Tunisia. He obtained his HDR in Environmental Geochemistry from the Faculty of Sciences of Sfax, in 2007. He obtained his MSc and PhD in Environmental Sciences from the Faculty of Sciences of Tunis, in 1996 and 2000, respectively. He obtained his Diploma in Geological Engineering from the National School of Engineering of Sfax, in 1992. He is presently involved in teaching courses related to Air, Water and Soil pollution. His research interests deal mainly with the physical chemistry of the atmosphere, the impact of air and water pollution on the environment, and statistical analysis of environmental data. Md. Badiuzzaman Khan Khan is a professor and the former head of Bangladesh Agricultural University's Department of Environmental Science. In 2016, He earned a PhD in Environmental Science from Ca Foscari University in Italy, with a focus on organic contaminants in atmospheric aerosols. From 2005 to 2006, he was a visiting scientist at NIAES in Japan, conducting research on CO2 flow studies in Bangladesh. He began his career as a lecturer in 2005 at the Department of Environmental Science, Bangladesh Agricultural University and pursued his MSc from the university of Manchester in 2010. He has published 45 publications in peer-reviewed international journals, and these papers have been extensively cited in the literature on air quality monitoring by peers from all around the world. Additionally, this research was strongly promoted by the government of Bangladesh, which resulted in my successfully completing six important projects over the last five years. BAURES (2016-2017; 2019-2020); UGC (2018-2019); MOST (2019-2020); ICT (2019-2020); MoE (2020-2022) and the Ministry of Planning (2020-2021) were among the funding agencies. These research studies were presented in a variety of national and international venues. Moreover, He is also working as a guest Editor of a reputed journal.
1. Introduction to Bioaerosols and Indoor Air Quality 2. Sources of Bioaerosols in Indoor Environments 3. Transport Mechanisms of Bioaerosols 4. Microbial Air Contamination in Indoor Spaces 5. Air conditioning Systems and Their Role in Indoor Air Quality 6. Health Implications of Bioaerosol Exposure 7. Monitoring and Measurement Techniques for Bioaerosols 8. Standards and Guidelines for Indoor Air Quality 9. Mitigation Strategies for Bioaerosol Control 10. Advances in Air Purification Technologies 11. Future Directions and Research Opportunities in Bioaerosols and Indoor Air Quality
| Erscheint lt. Verlag | 19.3.2026 |
|---|---|
| Zusatzinfo | 4 Tables, black and white; 2 Line drawings, black and white; 4 Halftones, black and white; 6 Illustrations, black and white |
| Verlagsort | London |
| Sprache | englisch |
| Maße | 156 x 234 mm |
| Themenwelt | Naturwissenschaften ► Chemie ► Technische Chemie |
| Technik ► Bauwesen | |
| ISBN-10 | 1-041-11011-1 / 1041110111 |
| ISBN-13 | 978-1-041-11011-8 / 9781041110118 |
| Zustand | Neuware |
| Informationen gemäß Produktsicherheitsverordnung (GPSR) | |
| Haben Sie eine Frage zum Produkt? |
aus dem Bereich


